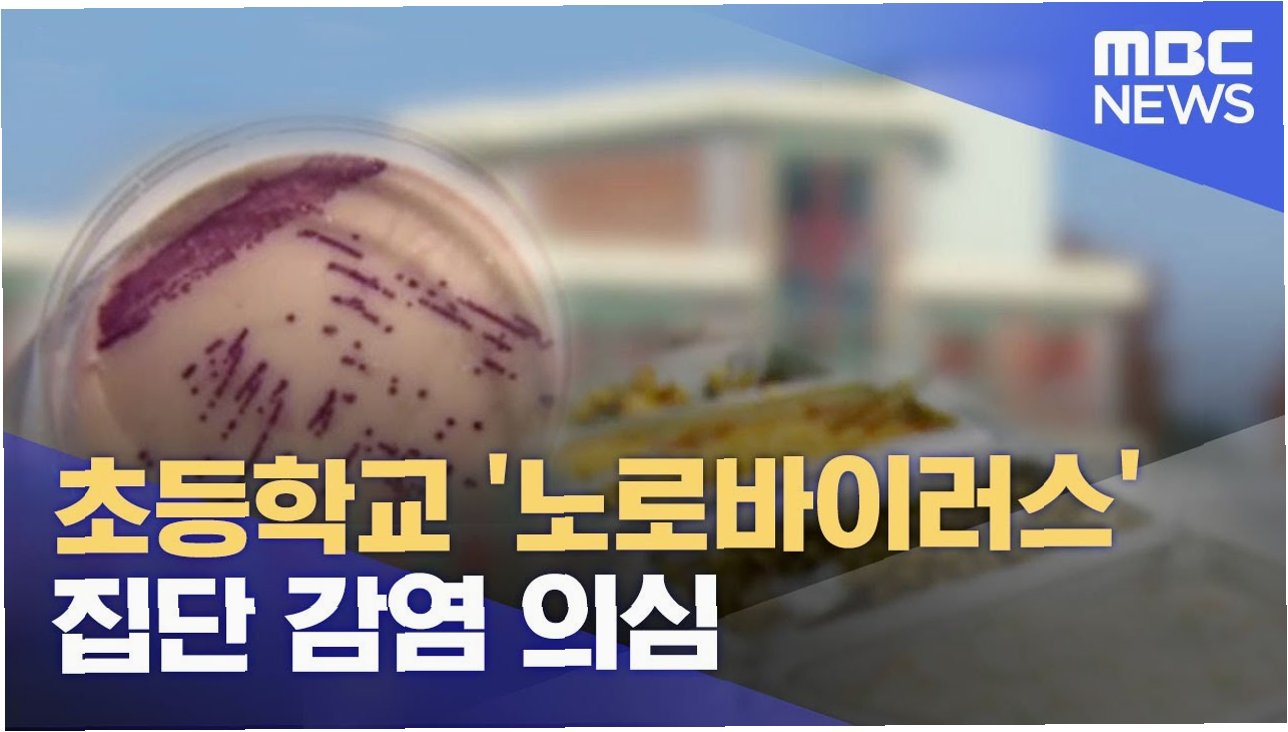

결혼식, 행복의 시작이 악몽으로 변하다
사랑하는 사람과의 아름다운 시작을 약속하는 결혼식. 하지만 이 설렘이 악몽으로 변하는 순간이 있습니다. 최근 일본에서 열린 한 결혼식에서 53명의 하객 중 무려 27명이 노로바이러스에 집단 감염되는 충격적인 사건이 발생했습니다. 이 소식은 결혼식의 기쁨을 뒤덮고, 우리에게 건강과 위생의 중요성을 다시 한번 깨닫게 해줍니다.

결혼식장의 은밀한 그림자: 노로바이러스의 습격
사건의 발단은 홋카이도 삿포로시의 한 결혼식장이었습니다. 지난 6일에 열린 이 결혼식에 참석한 53명 중 27명이 갑작스러운 발열, 구토, 설사 증세를 보이며 병원을 찾았습니다. 검사 결과, 이들의 대변에서 노로바이러스가 검출되었고, 이는 결혼식에 참석한 하객들에게 끔찍한 고통을 안겨주었습니다. 결혼식은 행복한 순간을 기념하는 자리이지만, 때로는 예상치 못한 위험이 도사리고 있을 수 있다는 것을 보여주는 사례입니다.

무방비 상태의 위생: 치명적인 소독의 실수
이번 집단 감염의 원인은 치명적인 소독 실수였습니다. 결혼식장에서는 노로바이러스에 효과가 없는 에탄올로 소독을 진행했습니다. 5일 전 열린 다른 결혼식에서 참석자가 데려온 영아가 배변을 한 사건이 있었고, 이를 처리하는 과정에서 부적절한 소독이 이루어진 것입니다. 삿포로시 보건소는 이러한 소독 불충분을 집단 감염의 주요 원인으로 지목했습니다. 이는 우리에게 올바른 위생 관리의 중요성을 강조하며, 작은 실수가 얼마나 큰 결과를 초래할 수 있는지 보여줍니다.

노로바이러스의 공포: 증상과 감염 경로
노로바이러스는 오염된 물이나 음식물을 통해 감염되며, 환자와의 접촉을 통해서도 전파될 수 있습니다. 감염되면 12~48시간 이내에 구토, 설사 등의 증상이 나타나며, 복통, 오한, 발열이 동반될 수도 있습니다. 다행히 대부분 2~3일 내에 회복되지만, 면역력이 약해 재감염될 가능성도 있습니다. 특히 이번 사건처럼 집단 감염의 경우, 개인뿐만 아니라 주변 사람들에게도 큰 피해를 줄 수 있습니다. 따라서 예방 수칙을 준수하고, 감염 시 적절한 조치를 취하는 것이 중요합니다.

예방이 최선: 건강한 결혼식을 위한 안전 수칙
결혼식과 같은 다중이용시설에서는 철저한 위생 관리가 필수적입니다. 노로바이러스 예방을 위해서는 올바른 손 씻기, 음식 익혀 먹기, 식기류 소독 등 기본적인 위생 수칙을 준수해야 합니다. 특히, 에탄올 소독은 노로바이러스에 효과가 없으므로, 염소계 표백제와 같은 적절한 소독제를 사용하는 것이 중요합니다. 또한, 의심 증상이 나타나면 즉시 의료기관을 방문하여 진료를 받는 것이 필요합니다. 건강한 결혼식을 만들기 위해서는 개인의 노력뿐만 아니라, 시설 운영자의 책임감 있는 위생 관리도 중요합니다.
결혼식, 안전과 행복을 함께
이번 사건은 결혼식이라는 특별한 순간에도 건강과 안전이 얼마나 중요한지를 다시 한번 일깨워줍니다. 행복한 결혼식을 위해서는 즐거움뿐만 아니라, 위생과 안전에도 각별한 주의를 기울여야 합니다. 꼼꼼한 위생 관리와 예방 수칙 준수를 통해, 모든 결혼식이 축복과 기쁨으로 가득 찰 수 있도록 노력해야 합니다. 우리 모두의 노력을 통해, 결혼식의 아름다운 기억만이 영원히 남을 수 있기를 바랍니다.

핵심만 콕!
일본 결혼식에서 발생한 노로바이러스 집단 감염 사건은 부적절한 소독으로 인한 위생 관리의 중요성을 강조합니다. 27명의 하객이 감염되었으며, 올바른 위생 수칙 준수와 적절한 소독을 통해 이러한 위험을 예방해야 합니다.

자주 묻는 질문
Q.노로바이러스는 어떻게 감염되나요?
A.노로바이러스는 오염된 음식이나 물을 섭취하거나, 감염된 사람과의 접촉을 통해 감염됩니다.
Q.노로바이러스 감염 시 증상은 무엇인가요?
A.구토, 설사, 복통, 오한, 발열 등의 증상이 나타날 수 있습니다.
Q.노로바이러스 예방을 위해 무엇을 해야 하나요?
A.손 씻기, 음식 익혀 먹기, 식기류 소독 등 기본적인 위생 수칙을 준수하고, 에탄올 대신 염소계 표백제와 같은 적절한 소독제를 사용해야 합니다.

'이슈' 카테고리의 다른 글
| 김민석 국무총리 후보자 청문회 공방: 자료 제출, 폄훼, 그리고 진실 공방 (1) | 2025.06.25 |
|---|---|
| 7월, '갤S25 공짜폰' 전쟁? 통신3사 보조금 경쟁, 소비자는 웃을까 (1) | 2025.06.25 |
| 아랫집 '무개념 담배충'과의 전쟁: 쾌적한 집, 어떻게 되찾을까? (1) | 2025.06.25 |
| 충격! 회전초밥집 투입구에 콘돔? 일본을 뒤흔든 '장난'의 대가 (1) | 2025.06.25 |
| 조현 외교부 장관 후보자의 10억 차익 논란 해명: 투기는 아니었다? (1) | 2025.06.25 |